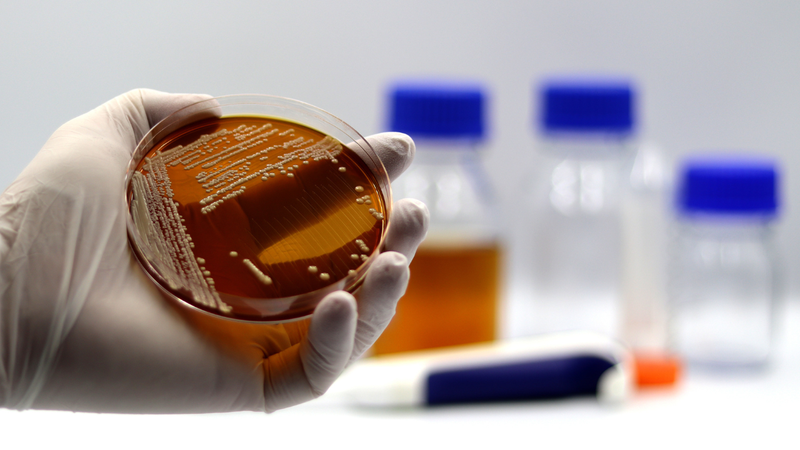
Saccharomyces boulardii: "Vệ sĩ" bảo vệ đường ruột 1

28/04/2025
Mặc định
Lớn hơn
Saccharomyces boulardii là một loại nấm men vi sinh có lợi, đóng vai trò như một "vệ sĩ" bảo vệ đường ruột. Khác với những lợi khuẩn thông thường (là vi khuẩn), Saccharomyces boulardii là nấm men sống, có khả năng đối kháng và ức chế sự phát triển của các vi khuẩn gây hại trong hệ tiêu hóa.
Saccharomyces boulardii là một loại nấm men vi sinh có lợi, được phân lập lần đầu tiên vào năm 1920 bởi nhà khoa học người Pháp Henri Boulard từ vỏ quả vải và măng cụt. Khác với các probiotic thông thường là vi khuẩn, S. boulardii là nấm men, có khả năng sống sót trong môi trường axit của dạ dày và không bị tiêu diệt bởi kháng sinh. Điều này giúp S. boulardii trở thành một lựa chọn hiệu quả trong việc hỗ trợ điều trị các rối loạn tiêu hóa, đặc biệt là tiêu chảy do kháng sinh, tiêu chảy du lịch và tiêu chảy do Clostridium difficile.
Ngoài ra, S. boulardii còn giúp cân bằng hệ vi sinh đường ruột, tăng cường hàng rào bảo vệ niêm mạc ruột và hỗ trợ hệ miễn dịch. Nhờ những đặc tính này, S. boulardii được ứng dụng rộng rãi trong các sản phẩm men vi sinh và thực phẩm chức năng nhằm cải thiện sức khỏe tiêu hóa.
Việc sản xuất S. boulardii đòi hỏi quy trình nghiêm ngặt để đảm bảo chất lượng và hiệu quả của sản phẩm. Quá trình này bao gồm:
Nuôi cấy: S. boulardii được nuôi cấy trong môi trường giàu dinh dưỡng, thường là môi trường chứa glucose và các yếu tố vi lượng cần thiết.
Thu hoạch: Sau khi đạt mật độ tế bào mong muốn, nấm men được thu hoạch bằng cách ly tâm hoặc lọc.
Làm khô: Nấm men sau khi thu hoạch được làm khô bằng phương pháp sấy lạnh hoặc sấy phun để giữ nguyên hoạt tính sinh học.
Đóng gói: Sản phẩm cuối cùng được đóng gói trong điều kiện vô trùng để đảm bảo độ ổn định và thời gian sử dụng.
Một số nghiên cứu gần đây cũng tập trung vào việc cải thiện khả năng chịu nhiệt và axit của S. boulardii thông qua kỹ thuật di truyền, nhằm tăng cường hiệu quả và độ bền của sản phẩm.
S. boulardii phát huy tác dụng thông qua nhiều cơ chế khác nhau:
Nhờ những cơ chế này, S. boulardii không chỉ hỗ trợ điều trị các rối loạn tiêu hóa mà còn góp phần duy trì sức khỏe tổng thể của hệ tiêu hóa.
Saccharomyces boulardii là một loại nấm men vi sinh có lợi, được sử dụng rộng rãi trong y học để hỗ trợ và điều trị các vấn đề liên quan đến hệ tiêu hóa.

Cách dùng
Sản phẩm thường có dạng viên nang hoặc bột. Đối với trẻ nhỏ, có thể trộn bột với sữa hoặc thức ăn để dễ dàng sử dụng. S. boulardii có thể được uống trước hoặc sau bữa ăn. Tuy nhiên, để giảm thiểu tác động của axit dạ dày, nên uống cùng hoặc ngay sau bữa ăn.
Liều dùng
Đối với người lớn và trẻ em trên 12 tuổi, liều dùng phổ biến là 250 mg/lần, 1 – 2 lần mỗi ngày. Đối với trẻ em từ 2 – 12 tuổi, liều dùng tương tự. Trẻ dưới 2 tuổi nên tham khảo ý kiến bác sĩ trước khi sử dụng.
Lưu ý: Không nên sử dụng S. boulardii cho những người có hệ miễn dịch suy yếu hoặc đang sử dụng catheter tĩnh mạch trung tâm, do nguy cơ nhiễm nấm huyết.
Nếu bạn cần thêm thông tin chi tiết hoặc có thắc mắc cụ thể, hãy tham khảo ý kiến của chuyên gia y tế hoặc bác sĩ chuyên khoa.

Saccharomyces boulardii là một loại nấm men probiotic được sử dụng rộng rãi trong nhiều lĩnh vực nhờ vào khả năng hỗ trợ sức khỏe tiêu hóa và tăng cường hệ miễn dịch.
S. boulardii được ứng dụng trong sản xuất các sản phẩm như kefir, sữa chua, và các loại đồ uống lên men khác. Việc bổ sung nấm men này không chỉ cải thiện hương vị mà còn tăng cường giá trị dinh dưỡng và lợi ích sức khỏe của sản phẩm.
S. boulardii được sử dụng để tạo ra các sản phẩm thực phẩm chức năng nhằm hỗ trợ sức khỏe tiêu hóa và tăng cường hệ miễn dịch.
Một số nghiên cứu cho thấy S. boulardii có thể giúp cải thiện các tình trạng viêm da như viêm da dị ứng bằng cách điều hòa phản ứng viêm và tăng cường hàng rào bảo vệ da.
Hỗ trợ điều trị tiêu chảy: S. boulardii được sử dụng để phòng ngừa và điều trị tiêu chảy do nhiều nguyên nhân khác nhau, bao gồm tiêu chảy do sử dụng kháng sinh, tiêu chảy du lịch, và tiêu chảy do nhiễm Clostridium difficile.
Hỗ trợ điều trị các bệnh đường tiêu hóa: Nấm men này cũng được nghiên cứu trong việc hỗ trợ điều trị các bệnh như hội chứng ruột kích thích (IBS), viêm loét đại tràng, và bệnh Crohn.

Mặc dù S. boulardii được coi là an toàn cho hầu hết người dùng, nhưng cần lưu ý một số điểm sau:
